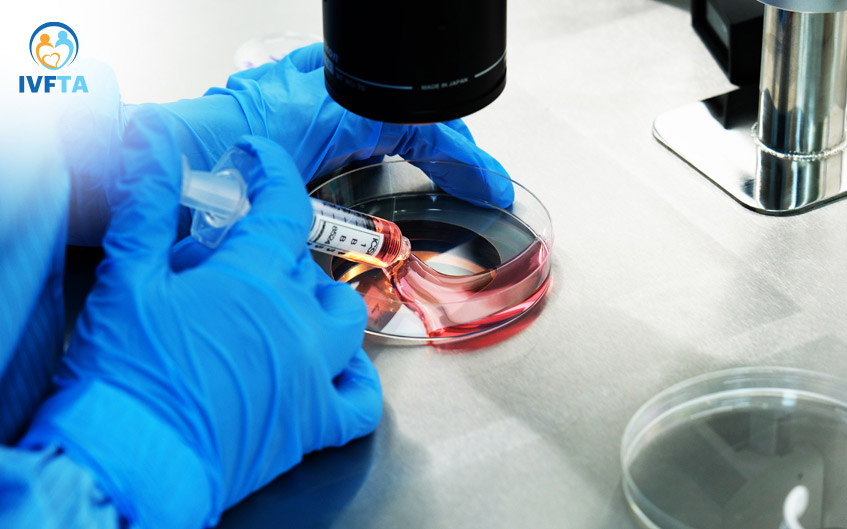

Trữ phôi là quá trình bảo quản và lưu trữ phôi “để dành” sử dụng trong tương lai. Xu hướng trữ phôi không chỉ được chỉ định cho các cặp đôi thực hiện thụ tinh trong ống nghiệm IVF mà còn mở ra cơ hội cho nhiều người muốn bảo tồn khả năng sinh sản, chưa phù hợp để có con ở thời điểm hiện tại.

Bài viết được tư vấn chuyên môn bởi BS Phạm Thị Mỹ Tú, Trung tâm Hỗ trợ sinh sản, Bệnh viện Đa khoa Tâm Anh Tp. Hồ Chí Minh
Trữ phôi (hay còn gọi đông lạnh phôi, bảo quản lạnh phôi) là một quá trình bảo quản và lưu trữ phôi để sử dụng trong tương lai.
Bệnh nhân được chỉ định dùng thuốc kích thích buồng trứng để có khả năng gom được nhiều trứng hơn. Sau đó, trứng được thụ tinh với tinh trùng và tạo thành phôi. Các phôi này tiếp tục được bảo quản lạnh bằng kỹ thuật thủy tinh hóa hoặc phương pháp đông lạnh chậm và chuyển sang bể chứa đầy nitơ lỏng, nhiệt độ -196 độ C để bảo quản lâu dài.
Trữ phôi là cách giúp nhiều người có khả năng sinh sản, cũng như bảo tồn cơ hội có con trong tương lai. Đây là phương pháp thường sử dụng trong chu kỳ IVF, được đánh giá an toàn, hiệu quả. Các nghiên cứu và thực tế lâm sàng đều đánh giá việc trữ đông phôi không làm ảnh hưởng đến chất lượng phôi. (1)
Phôi trữ đông (phôi đông lạnh) là khái niệm chỉ những phôi (trứng đã được thụ tinh) trữ lạnh thay vì chuyển vào cơ thể người mẹ. Khác với khái niệm phôi tươi, phôi trữ đông thường được bảo quản trong các thiết bị, máy móc chuyên dụng sau quy trình thực hiện thụ tinh trong ống nghiệm (IVF), chờ ngày được chuyển vào cơ thể người mẹ để phát triển thành thai nhi.
Phôi được tạo thành bằng cách tiêm tinh trùng vào tế bào chất của trứng (Intracytoplasmic Sperm Injection – ICSI) trong phòng thí nghiệm, các chuyên viên phôi học sẽ tiếp tục theo dõi tế bào phân chia và đánh giá quá trình phát triển sau đó.
Các phôi chất lượng cao được chuyển vào tử cung người mẹ để bắt đầu quá trình phát triển thành thai nhi, hoặc sẽ chuyển vào các tủ đông lưu trữ, chờ ngày được chuyển vào cơ thể mẹ và bắt đầu cuộc sống mới.
Kỹ thuật trữ đông phôi thường được thực hiện sau khi một người cố gắng mang thai bằng các phương pháp hỗ trợ sinh sản như thụ tinh trong ống nghiệm (IVF), tiêm tinh trùng vào bào tương trứng (ICSI)… Sau quá trình thụ tinh ống nghiệm, các phôi chưa được sử dụng đến có thể được trữ đông lạnh để sử dụng cho lần chuyển phôi tiếp theo.
Những lý do bạn nên thực hiện kỹ thuật trữ đông phôi:

Ngày nay, không chỉ những cặp vợ chồng hiếm muộn mới cần thiết trữ đông phôi hoặc trứng. Lựa chọn trữ đông phôi là một biện pháp nhằm bảo tồn khả năng sinh sản.
Các trường hợp bệnh nhân điều trị ung thư, các bệnh lý nguy hiểm khác cần điều trị bằng hóa – xạ trị; bệnh nhân chưa có dự định mang thai trong tương lai gần; phụ nữ chuyển giới sang nam có thể lựa chọn trữ phôi hoặc trứng trước khi sử dụng các hormone, phẫu thuật chuyển giới…
Quy trình trữ phôi phụ thuộc vào phương pháp đông lạnh. Hiện nay có 2 phương pháp chính bao gồm: Đông lạnh chậm và Thủy tinh hóa:
Phôi sẽ được hạ nhiệt độ từ từ theo chu trình hạ nhiệt đã được hệ thống cài đặt sẵn. Quá trình này kéo dài khoảng 2 giờ và hoàn tất khi nhiệt độ hạ đến mức lý tưởng -196 độ C (-321 độ F) và được bảo quản trong nitơ lỏng. Phương pháp này có tác dụng ngăn chặn các tế bào của phôi khỏi quá trình lão hóa, giảm rủi ro phôi bị hư hỏng.
Quá trình làm đông lạnh chậm được thực hiện như sau:
Là phương pháp hiện đại hơn, được đánh giá ưu việt hơn so với phương pháp đông lạnh truyền thống. Để trữ phôi bằng phương pháp thủy tinh hóa, bác sĩ hạ nhiệt độ nhanh đến mức các phân tử nước trong trứng/ phôi không có thời gian hình thành tinh thể băng.
Sau đó chúng sẽ được đặt vào các thùng trữ phôi chứa nitơ lỏng ở nhiệt độ -196 độ C và đóng băng thành một chất giống thủy tinh. Phương pháp thủy tinh hóa khắc phục được tình trạng tế bào bị tổn thương do các tinh thể băng tác động, nâng cao tỷ lệ phôi sống và khả năng lên phôi sau khi rã đông.
Trong quá trình thủy tinh hóa phôi, các bác sĩ hỗ trợ sinh sản tiến hành:
Công nghệ đông lạnh phôi, trứng ngày càng tiến bộ mang đến nhiều cơ hội thành công cho những người đang mong muốn có con bằng phương pháp hỗ trợ sinh sản cũng như bảo tồn chức năng sinh sản của người phụ nữ. Trữ đông lạnh phôi sở hữu những ưu điểm như:
Nhờ sự tiến bộ của các phương pháp, kỹ thuật tiên tiến, ngày nay việc trữ đông phôi được đánh giá an toàn và hiệu quả. Rủi ro của quá trình trữ đông thường chỉ liên quan đến thủ thuật chọc hút trứng, bao gồm:
Mặc dù vậy, những trường hợp này hiếm khi xảy ra. Tại IVFTA, bệnh nhân được thăm khám, kiểm tra kỹ càng trước khi thực hiện các công đoạn chọc hút trứng, tạo phôi và trữ phôi.
Hệ thống bình trữ lạnh phôi luôn đạt tiêu chuẩn kiểm định chất lượng, tạo môi trường tối ưu cho việc bảo quản phôi luôn trong tình trạng tốt nhất, đạt hiệu quả tối ưu khi rã đông và chuyển vào cơ thể người mẹ.
Trước đây, công nghệ làm đông lạnh chậm được sử dụng trong trữ đông trứng hoăc phôi. Các tế bào được làm lành rất chậm trong vài giờ cho đến khi đạt nhiệt độ thích hợp để bảo quản tối ưu.
Phôi được đánh giá có khả năng sống sót trong quá trình đông lạnh và rã đông tốt hơn trứng. Điều này xuất phát từ lý do trứng là những tế bào có kích thước lớn, hàm lượng nước cao nên dễ bị hình thành tinh thể băng, gây tổn thương tế bào.
Ngược lại, phôi là trứng đã được thụ tinh và phân chia thành các tế bào nhất định trước khi đem đi trữ đông lạnh. Do đó chúng ít bị ảnh hưởng hơn.
Tuy nhiên, sự ra đời của phương pháp thủy tinh hóa (làm lạnh nhanh) đã loại bỏ sự khác biệt này trong quá trình trữ đông trứng. Hiện nay, tỷ lệ sống sót khi đông lạnh trứng so với phôi tương đối giống nhau.
Một báo cáo năm 2012 tại Anh chỉ ra rằng những đứa trẻ sinh ra từ phôi đông lạnh có cân nặng lớn hơn (hơn 253g) và thời gian mẹ mang thai cũng lâu hơn (0,65 tuần) so với những đứa trẻ sinh ra từ phôi tươi. Đồng thời, tỷ lệ trẻ sơ sinh nhẹ cân (dưới 2,5kg) cũng thấp hơn ở nhóm này (3,7% so với 10,7% ở trẻ sinh từ phôi tươi). (4)
Lý giải cho kết quả này, các nhà khoa học Đan Mạch cho rằng những phôi chất lượng tốt nhất mới có thể tồn tại trong quá trình đông lạnh và rã đông. Điều này đồng nghĩa rằng những đứa trẻ sinh ra từ phôi trữ đông có thể khỏe mạnh hơn so với phôi tươi.
Do đó với thắc mắc phôi trữ đông có tốt không mà nhiều cặp vợ chồng đang lăn tăn, bác sĩ Phạm Thị Mỹ Tú cho biết với trình độ phát triển y khoa hiện nay cùng sự cập nhật tiến bộ kỹ thuật nhanh chóng, ba mẹ có thể tin tưởng chất lượng phôi trữ đông cũng như sức khỏe của trẻ sinh ra từ phương pháp thụ tinh ống nghiệm không khác biệt so với những trẻ sinh ra bằng phương pháp tự nhiên.
>> Xem thêm: Phôi trữ đông có sàng lọc được không? Kết quả như thế nào?
Thậm chí một số nghiên cứu chỉ ra rằng chuyển phôi trữ đông giúp tăng cơ hội mang thai ở người phụ nữ nhờ đạt các điều kiện phù hợp trước khi chuyển phôi vào buồng tử cung.
Về lý thuyết, phôi có thể “được lưu trữ vô thời hạn” bằng các phương pháp đông lạnh hiện đại. Phôi đông lạnh thường được lưu trữ và theo dõi tại các phòng labo của trung tâm hỗ trợ sinh sản.
Thời gian trữ phôi có thể lên đến 10 năm, thậm chí lâu hơn. Trong suốt thời gian này, phôi cần đảm bảo được bảo quản trong nitơ lỏng ở nhiệt độ âm 320 độ F (âm 196 độ C), tránh xa bức xạ ion hóa từ mặt trời

Một báo cáo gần nhất cho biết, năm 2020 tại Mỹ, một bé gái được sinh ra khỏe mạnh từ phôi trữ lạnh suốt 27 năm. Đến thời điểm hiện tại, đây được xem là trường hợp phôi thai đông lạnh lâu nhất trước khi chào đời.
Không có bất kỳ bằng chứng nào cho thấy sức khỏe của những đứa trẻ sinh ra từ phôi đông lạnh khác biệt so với những trẻ được sinh ra từ quá trình chuyển phôi tươi. Do đó ba mẹ không nên quá lo lắng về chất lượng phôi đông lạnh cũng như sức khỏe, tinh thần của trẻ sinh ra từ phôi trữ đông.
Một bất lợi đối với phôi đông lạnh là chúng có thể bị tổn thương trong quá trình đông lạnh/rã đông. Tuy nhiên, các nghiên cứu cho thấy phôi đông lạnh có tỷ lệ sống sót lên đến 95%, vì vậy tỷ lệ rủi ro rất nhỏ.
Ngoài ra công nghệ tiên tiến thủy tinh hóa được áp dụng trong quá trình đông lạnh phôi giúp bảo toàn chất lượng phôi, tránh làm hỏng hoặc giảm chất lượng phôi khi chuẩn bị đưa vào cơ thể người mẹ.
Quá trình rã đông phôi đơn giản là đảo ngược quy trình đông lạnh. Theo đó, phôi được lấy ra từ thùng nitơ và được làm ấm đến nhiệt độ phòng trong 30 giây.
Trong 30 phút tiếp theo, phôi đông lạnh được đưa qua 4 dung dịch khác nhau cho đến khi chất bảo quản đông lạnh (CPA), hóa chất được sử dụng trong dung dịch đông lạnh để bảo vệ trứng được loại bỏ hoàn toàn và thay thế bằng nước.
Quy trình rã đông phôi được thực hiện ở nhiệt độ phòng, được làm ấm đến nhiệt độ 37 độ C (tương đương nhiệt độ cơ thể người mẹ).

Các bác sĩ Hỗ trợ sinh sản tiếp tục đánh giá chất lượng phôi lần cuối trước khi tiến hành chuyển phôi. Phôi rã đông có thể chuyển vào tử cung người phụ nữ sau ít nhất 40 phút lấy ra từ nơi trữ lạnh.
Một báo cáo thống kê tại Úc năm 2022 cho thấy, tỷ lệ chuyển phôi trữ đông lạnh thành công dao động từ 60% đối với những bệnh nhân dưới 30 tuổi, đến 53% cho những bệnh nhân trên 42 tuổi.
Tỷ lệ thành công được đánh giá trên các tiêu chí phôi có trứng được thụ tinh trong ống nghiệm IVF và những phôi được thụ tinh bằng kỹ thuật tiêm tinh trùng vào bào tương noãn (ICSI), cũng như phôi đã được xét nghiệm di truyền tiền làm tổ.
Một nghiên cứu trên Thư viện Y khoa Quốc gia Mỹ (NIH) cho biết có sự khác biệt về tỷ lệ thành công giữa nhóm chuyển phôi tươi và nhóm chuyển phôi đông lạnh. Theo đó tỷ lệ có thai lần lượt là 35.46% đối với trường hợp chuyển phôi tươi và 47.47% đối với trường hợp chuyển phôi trữ đông lạnh. Tỷ lệ mang thai cộng dồn cũng cao hơn 23.11%.
Một nghiên cứu khác năm 2017 cũng cho biết tỷ lệ có thai ở nhóm chuyển phôi đông lạnh (52%) cao hơn so với nhóm phôi tươi (45.3%).
Tóm lại, dựa vào các kết quả báo cáo cho thấy phôi trữ đông vẫn đảm bảo chất lượng tốt, khả năng làm tổ và phát triển cao trong tử cung người mẹ. Chính vì vậy bạn không cần lo lắng trữ đông phôi làm giảm chất lượng phôi.
Chi phí trữ phôi đông lạnh tại IVFTA là bao nhiêu luôn là thắc mắc của nhiều người khi tìm hiểu về quá trình trữ phôi tại Trung tâm Hỗ trợ sinh sản, Bệnh viện Đa khoa Tâm Anh.
Hiện nay, chi phí trữ lạnh phôi lần đầu tiên tại IVFTA có giá là 4,6 triệu/1tec/6 tháng. Chi phí trữ phôi có thời hạn 6 tháng kể từ thời điểm trữ phôi. Khách hàng có nhu cầu tiếp tục trữ đông phôi cần đóng thêm phí gia hạn sau mỗi 6 tháng.
Lưu ý:
>> Xem thêm: Chi phí làm IVF hết bao nhiêu tiền? 7 yếu tố tác động bảng giá
Hiện nay, IVFTA là một trong những trung tâm hỗ trợ sinh sản được chú trọng đầu tư bài bản hệ thống phòng sạch, đạt tiêu chuẩn nuôi cấy phôi ổn định, duy trì nhiệt độ và điều kiện tối ưu cho quá trình nuôi cấy và trữ phôi.
Đặc biệt, thiết kế hệ thống Lab-in-a-Lab đầu tiên tại Đông Nam Á giúp IVF Tâm Anh TP.HCM đảm bảo những tiêu chuẩn cao nhất, nghiêm ngặt nhất, mang tính đặc thù riêng của phòng Lab phục vụ hỗ trợ sinh sản.
Khu vực Lab ISO 5 đầu tiên tại khu vực luôn duy trì nhiệt độ ổn định, luồng không khí sạch, hạn chế tối thiểu các yếu tố nguy cơ ảnh hưởng đến quá trình nuôi cấy và phát triển phôi. Đây là khu vực ổn định giúp nuôi phôi ngày 3-5 hiệu quả, chất lượng nhờ giảm các xác trộn từ các tác động bên ngoài.

Đồng thời, hệ thống tủ nuôi cấy phôi dưới sự hỗ trợ của hệ thống timelapse có camera theo dõi kết hợp trí tuệ nhân tạo AI có thể theo dõi phôi phát triển liên tục.
Từ đó các bác sĩ hỗ trợ sinh sản và chuyên gia phôi học có căn cứ đưa ra đánh giá quá trình tế bào phân chia, tinh tuyển và lựa chọn được những phôi tiềm năng nhất để gia tăng tỷ lệ chuyển phôi thành công.
Đây được đánh giá là bước tiến vượt bậc mang lại nhiều cơ hội “tìm con” thành công hơn so với hệ thống nuôi cấy bằng tủ truyền thống chỉ đánh giá được hình thái phôi.
Sau khi được thụ tinh trong ống nghiệm, các phôi có chất lượng đạt chuẩn sẽ được tiến hành trữ đông. Khi bệnh nhân mong muốn tiếp tục mang thai, phôi sẽ được rã đông và chuyển vào buồng tử cung của người mẹ. Các phôi trước khi chuyển sẽ được đánh giá lại một lần nữa nhằm kiểm tra khả năng sống. Theo các nghiên cứu, 98% phôi sẽ sống sau quá trình rã đông.
Để tìm hiểu quy trình trữ phôi tại Trung tâm hỗ trợ sinh sản, Bệnh viện Đa khoa Tâm Anh, bạn có thể liên hệ qua thông tin sau:
HỆ THỐNG BỆNH VIỆN ĐA KHOA TÂM ANH
Trữ phôi là một giai đoạn quan trọng nhằm hỗ trợ tối ưu quá trình thụ tinh trong ống nghiệm cũng như bảo tồn chức năng sinh sản của nhiều người trong tương lai. Hy vọng bài viết cung cấp các thông tin chi tiết để bạn đưa ra những lựa chọn thích hợp cho hành trình trữ đông lạnh phôi, chuẩn bị cho hành trình làm cha, làm mẹ trong tương lai.